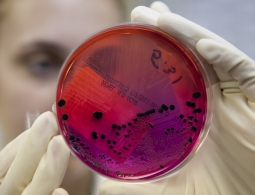
Обнаружен новый опасный штамм сибирской язвы

Найден способ «перепрограммировать» клетки для лечения заболеваний
Ни для кого не секрет, что клетки нашего организма имеют «встроенную» способность противостоять различным негативным факторам. Но, к сожалению, не всегда эта полезная функция позволяет в полной мере «отбить атаку». Тогда на помощь приходят различные лекарственные средства. Но...
Человек все-таки может усваивать новую информацию во время сна
Сну издревле приписывали самые разные свойства: от вполне обычной функции отдыха до магических и даже описания того, что во время сна душа покидает тело. Но одним из самых распространённых современных убеждений является, пожалуй, то, что во сне можно выучить огромные объемы информации. И вот, как пи...
В Китае построят «марсианскую» базу
Новостное агентство «Синьхуа» сообщает, что учёные исследуют северо-запад провинции Куингхай на предмет возможной постройки «марсианской» базы в местных красных горах. Власти уже дали добро на проведение строительства, ведь горный ландшафт севера провинции очень напоминает ма...
Разработано лекарство против рака на основе золота
Одним из самых эффективных средств лечения онкологических заболеваний на данный момент является химиотерапия. И при всех своих достоинствах есть у нее существенный недостаток: крайне высокая токсичность для организма. Но вскоре, как сообщает журнал Angewandte Chemie, может быть создан целый ряд прот...
Ученые назвали одну из самых больших опасностей для человека
Социальная изоляция и одиночество представляют большую угрозу для человека, нежели ожирение. Воздействие этих факторов на общество растет с каждым годов и может представлять серьезную проблему. К такому выводу пришли американские психологи из Университета Бригама Янга....
Дополненную реальность теперь можно имплантировать прямо в глаза
Пока Google думает, что дальше делать со своими очками Glass, а Microsoft пытается снизить стоимость невероятно дорогой AR-гарнитуры HoloLens, американская офтальмологическая компания Omega Ophthalmics разработала очень любопытную платформу, при помощи которой в глазное яблоко можно будет имплантиро...
SpaceX выпустила деморолик будущего полёта Falcon Heavy
В SpaceX очень ждут запуска тяжёлой ракеты-носителя Falcon Heavy и подогревают интерес к этому событию разными способами. Вот, например, новый анимационный ролик, созданный художниками и дизайнерами компании, демонстрирующий старт и первую минуту полёта ракеты. В нём можно увидеть взлёт ра...
На Венере когда-то могли быть целые океаны воды
Мы привыкли думать, что среди планет Солнечной системы только Марс, если, конечно, не брать в расчет саму Землю, мог когда-то являться пристанищем для жизни. Однако, если верить последним данным, наша более крупная соседка, Венера, тоже когда-то могла иметь океаны воды. Новые компьютерные симуляции,...
Обнаружен новый опасный штамм сибирской язвы
Сибирская язва является одной из самых опасных болезней, способной в кратчайшие сроки спровоцировать начало масштабной эпидемии с большим количеством жертв. Как утверждает издание EurekAlert со ссылкой на журнал Nature, международной группе исследователей удалось установить, что в данный момент бакт...
Представлен «телепорт», способный переместить ДНК с Земли на Марс
При нынешнем развитии современных технологий космических путешествий, дорога до Марса займет очень много времени. Но ученые из калифорнийской компании Synthetic Genomics Inc. (SGI) предлагают для транспортировки примитивных форм жизни использовать что-то вроде «цифрового телепорта». Им у...
Ученые выяснили, как первый просмотр порно влияет на поведение мужчин
Психологи из США выяснили, что просмотр порнографии в раннем возрасте делает мужчину склонным к доминированию над женщинами, а ознакомление с ней в позднем возрасте превращает их в плейбоев и "казанов". О результатах своих наблюдений они рассказ...
SpaceX начнёт доставлять людей на МКС уже в 2018 году
О планах SpaceX стало известно из расписания частных полётов, которое космическое агентство NASA опубликовало недавно. Согласно имеющейся там информации, SpaceX начнёт совершать доставку экипажей на МКС уже летом следующего года. Кроме того, конкуренцию компании Илона Маска составит и Boei...